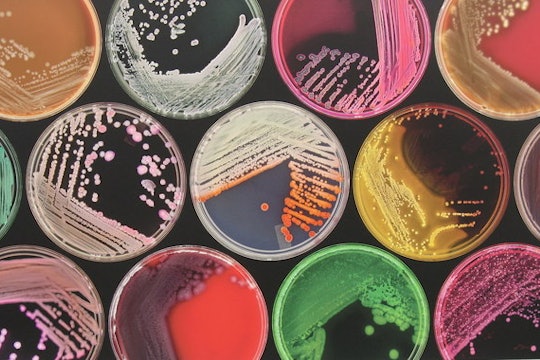

Photo © M J Richardson (cc-by-sa/2.0)

Produced in partnership with Two Photon
Es tiempo de incluir a nuestros amigos, los hongos, en nuestros microbiomas
El microbioma de nuestro intestino contiene hongos y protistas, no solo bacteria – entonces, ¿por qué no los estudiamos?
This article is available in English.
El microbioma de nuestro intestino está compuesto de millones de microbios microscópicos, como bacterias, hongos y protistas, los cuales llevan a cabo servicios que son esenciales para nuestra salud, por ejemplo, la digestión de nuestros alimentos y la protección contra ciertas infecciones. Si los hongos y los protistas son microbios, ¿por qué se les ha ignorado en la mayoría de los estudios del microbioma del intestino, y por qué estos estudios se han enfocado únicamente en bacterias? Los microbios interactúan en nuestro intestino de muchas formas, pero aún no entendemos por completo como lo hacen, y la única forma en que lograremos entenderlo es incluyendo hongos y protistas en la investigación del microbioma.

Escherichia coli
USDA ARS
Las bacterias son organismos unicelulares que son invisibles a simple vista y que abundan en nuestro intestino. Las bacterias reciben mucha atención porque pueden causar enfermedades, e incluso la muerte. Pero si continuamos enfocándonos solamente en este grupo de microbios en el microbioma, seguiremos contribuyendo al concepto equivocado de que solamente las bacterias habitan nuestros intestinos y que solo las bacterias importan en nuestra salud. Este tipo de falacias han promovido modas peligrosas que no están sustentadas en ciencia, por ejemplo, trasplantes fecales tipo “hágalo usted mismo”. Si continuamos ignorando que nuestros intestinos son ambientes complejos habitados por millones de microbios distintos, y favorecemos remedios de tipo casero, podemos poner nuestra vida en riesgo; no olvidemos que en nuestro intestino también pueden habitar organismos resistentes a antibióticos y virus, como el VIH y la hepatitis.
Los hongos y los protistas también pueden ser unicelulares e invisibles a simple vista. También son abundantes en nuestro intestino y también causan enfermedades en humanos, pero casi nunca son marcados como amenazas o peligrosos para nuestra salud. Sin embargo, los hongos, protistas y bacterias habitan el mismo espacio en nuestro intestino y comparten y compiten por los mismos recursos. A pesar de que estudiar a todos los microorganismos del microbioma es extremadamente difícil, es la única manera en la que comenzaremos a entender las interacciones complejas que ocurren entre ellos y, por lo tanto, mejorar la ciencia del microbioma.
Por ejemplo, al estudiar a los hongos y bacterias en el microbioma del intestino de personas con la enfermedad de Crohn, la cual consiste en inflamación crónica del tracto gastrointestinal, científicos encontraron que personas con la enfermedad de Crohn tenía menos bacterias y más hongos en su intestino en comparación con personas saludables. De hecho, hay evidencia que las crisis de la enfermedad de Crohn, las cuales se caracterizan por una intensificación de síntomas, están directamente relacionadas con el aumento de hongos en el intestino. Personas con diabetes tipo 1 y 2 muestran patrones similares. Es decir, tienen más hongos en el intestino en comparación con personas sin diabetes.
En este momento, no se sabe si esos cambios entre hongos y bacterias en el microbioma del intestino son simplemente el resultado de la enfermedad en progreso o si estos cambios están directamente relacionados con el desarrollo/inicio de la enfermedad. En el caso de protistas, es peor, ya que son totalmente ignorados en estudios del microbioma del intestino. Sin embargo, si logramos entender las dinámicas de los hongos y protistas en el microbioma de nuestro intestino, podremos empezar a comprender cual es el rol del microbioma en el desarrollo y progreso de ciertas enfermedades.

No se olviden de nosotros!
De momento, la interpretación de estudios del microbioma del intestino, deben ser tomados con precaución. No podemos asumir ni concluir nada conciso del microbioma del intestino y su asociación con enfermedades ni tratamientos para dichas enfermedades, hasta que comprendamos mejor como cada grupo de microbios se comporta y como interactúan entre ellos. A pesar de que hay modas de salud asociadas al “bacterioma”, es decir, las bacterias del intestino, no olvidemos que también hay millones de hongos y protistas que están siendo ignorados y que es tiempo de que se les tome en cuenta.